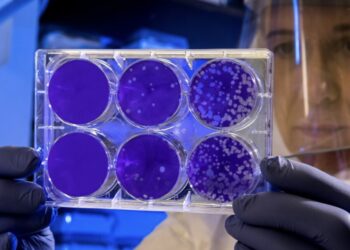

Histoires
Un test ADN a révélé la liaison que mon mari a entretenue pendant 22 ans avec ma mère.
Une Histoire de Trahison et de Résilience Dans le tourbillon des relations humaines, il arrive que nous fassions face à...
En savoir plusDetailsGénial ! Des stylistes transforment Rita, une sans-abri, en une belle femme
Le Pouvoir de la Transformation : L'Histoire de Rita Parfois, une seule opportunité peut radicalement changer une vie. C'est exactement...
En savoir plusDetailsLa « fille la plus poilue du monde » a décidé de s’épiler le visage. (Voici le résultat !)
Le Voyage Inspirant de Supatra Sasufan : Beauté et Résilience Supatra Sasufan, surnommée « la fille la plus poilue du...
En savoir plusDetailsDe l’enfant star à l’âge adulte : la vie d’Alana Thompson
La Transformation d'Alana Thompson : Un Voyage Vers le Bonheur Il y a onze ans, Alana Thompson, surnommée Honey Boo...
En savoir plusDetailsCes jumeaux ont été adorés et sont devenus célèbres. Que font-ils aujourd’hui ?
La Métamorphose de Dylan et Cole Sprouse : De l'Enfance à l'Adulte Les jumeaux Dylan et Cole Sprouse, autrefois des...
En savoir plusDetailsRenske (47) : « Pourquoi je suis contre les promenades d’automne en forêt – la nature n’est pas une attraction touristique ».
Le Respect de la Nature : Un Crie d'Algues de Renske Dans une petite ville paisible à la lisière de...
En savoir plusDetailsValentine (36) : « Le changement d’heure en hiver est démodé et devrait être supprimé ».
Faut-il vraiment maintenir le changement d'heure ? À l'approche de l'hiver, une chaude discussion émerge concernant le passage à l'heure...
En savoir plusDetailsLes gens ne croient pas que cette actrice enchantait le monde par son physique et son charme.
Dans le monde fascinant du cinéma, peu de figures ont connu une carrière aussi exaltante et tragique qu'Anita Ekberg. Née...
En savoir plusDetailsThéo (68 ans) : « Je donne de l’argent à mes petits-enfants au lieu de leur consacrer du temps parce que je n’ai pas envie de faire du baby-sitting tout le temps ».
La liberté d'un grand-père : Une réflexion sur les relations familiales Il est normal que les grands-parents ressentent un changement...
En savoir plusDetailsDe l’icône hollywoodienne à l’actrice méconnaissable grâce à la chirurgie esthétique
À 86 ans, Jane Fonda continue de captiver le monde avec sa présence éclatante. La célèbre actrice a récemment ébloui...
En savoir plusDetails